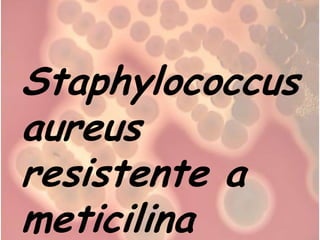
Staphylococcus
aureus
resistente a
meticilina
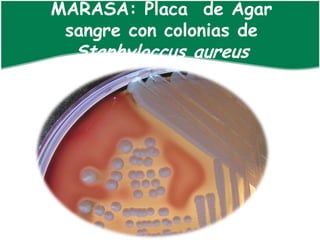
MARASA: Placa de Agar
 sangre con colonias de
  Staphyloccus aureus
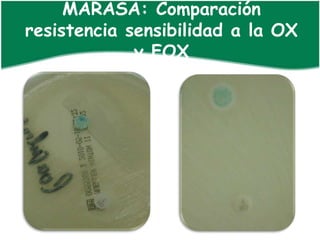
MARASA: Comparación
resistencia sensibilidad a la OX
             y FOX
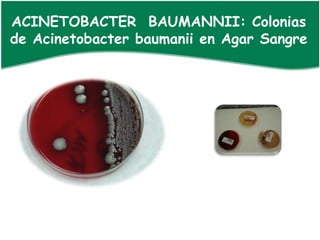
ACINETOBACTER BAUMANNII: Colonias
de Acinetobacter baumanii en Agar Sangre
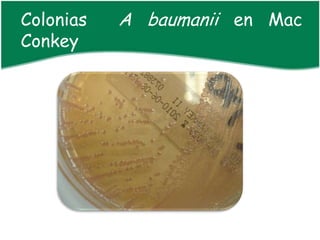
Colonias   A baumanii en Mac
Conkey

El documento aborda las infecciones nosocomiales causadas por microorganismos multiresistentes como Staphylococcus aureus resistente a meticilina (SAMR) y Acinetobacter baumannii, resaltando la importancia de la prevención mediante el lavado de manos y medidas de aislamiento. Además, se discute la resistencia antimicrobiana, su desarrollo y las consecuencias de su mal uso. Se concluye que la higiene y el uso adecuado de medidas de protección son esenciales para combatir estos organismos en entornos hospitalarios.